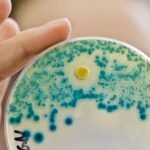

Multivitamin supplements offer key vitamins and minerals to strengthen body functions and maintain nutritional balance, supporting a more energetic lifestyle.
Product Suggestions Loading…
Feeling sluggish even after a whole night’s sleep? Low energy levels can often stem from missing essential nutrients in your diet. Multivitamins offer a practical solution, helping fill these nutritional gaps and supporting overall vitality. This article lists the 8 best multivitamin supplements 2025, focusing on options that may boost energy and complement a modern diet that may lack key vitamins and minerals.
While multivitamins can enhance your daily nutrition, they are not substitutes for a healthy lifestyle, balanced meals, or regular exercise. Always consult a healthcare professional before starting any new supplement, particularly if you have pre-existing medical conditions, to ensure safe and personalised guidance.
8 best multivitamin supplements in 2025:
1. HK Vitals Multivitamin (90 Tablets)
HK vitals multivitamin (90 tablets) is designed to help support the overall health of men and women. It contains all necessary vitamins and minerals, such as Zinc, Vitamin C, Vitamin D3, and Ginseng extract, and is thus used as a source of energy, vitality and daily nutrition. This multivitamin supplement is worth using by everyone who wants to support the immune system and improve overall well-being.
2. Vlado’s Himalayan Organics Multivitamin With Probiotics
The Himalayan Organics multivitamin with probiotics (180 veg tablets) by Vlado consists of 60 active ingredients, such as Vitamins C, D, E, B3, B5, B12, Zinc, Magnesium, Giloy, and Biotin. This combination helps strengthen bones and joints, maintain gut health, increase energy, and improve overall well-being. It is a well-rounded daily nutritional and health supplement suitable for both men and women.
3. Swisse Men’s Multivitamin -Manufactured In Australia, Imported Multivitamin
Swisse Men multivitamin (30 Tab) is an Australian-made vitamin supplement containing 35 essential vitamins, minerals, and herbs (Ginseng) to help men maintain daily health. Formulated to enhance energy, stamina, and vitality, it promotes overall wellness and supplements nutritional deficiencies in a modern diet. This imported multivitamin is perfect for men who need performance and well-balanced nutrition every day.
4. Fytika Vita 365-60 Tablets (Pack of 1) Multivitamin For Men and Women
Fytika Vita 365 (60 tablets) is a well-balanced multivitamin available for males and females that contains Ashvagandha, Ginseng, Probiotics, Prebiotics, and Biotin. It is formulated to be gently digested and helps to provide energy, immunity, and gut health. A balanced composition is vital to providing optimal absorption of essential nutrients. This multivitamin makes it an easy-to-consume daily supplement that contributes to overall well-being.
5. Neuherbs Multivitamin – 60 Tablets
Neuherbs Multivitamin (2 packs of 60 Tablets) is a daily multivitamin that promotes overall health in men and women. It is enriched with Vitamins C, B, D, Iron, and Zinc to increase energy, stamina, and well-being. It is ideal for people with nutritional deficiencies or busy schedules, as it promotes vitality, immunity, and daily balanced nutrition.
6. TrueBasics Advanced Multivitamin For Sports & Fitness (90 Tablets)
TrueBasics advanced multivitamin sports and fitness (90 tablets) is a blend of 24 basic vitamins and minerals and a combination of amino acids, energy, immunity, and antioxidants. It is best suited to support the energy levels, muscle relaxation, and general liveliness of active people, fitness enthusiasts, and athletes. This complete supplement assists in filling nutritional gaps and, therefore, is an intelligent option for anyone with an active, performance-oriented lifestyle.
7. OZiva Plant-Based Multivitamins for Women 35+
OZiva Women 35+ 50 vegetarian tablets multivitamins are specifically designed to maintain hormonal balance, bone health, and shiny skin and hair. This vegan supplement is enriched with Chasteberry, Vitamin E, and D3 to ensure that women in their mid-30s and older have the necessary vitamins and nutrients. Plant-based and health-oriented, it is a convenient method of remaining healthy in a natural way.
8. NUTRILITE Daily 120 tablets Multivitamin
NUTRILITE Daily Multivitamin & Multimineral Tablets (120 Tablets) combine balanced vitamins and minerals to promote overall health. These tablets are designed to support metabolism, maintain energy and well-being, and fill nutritional gaps in everyday diets. They are perfect for busy adults because they help enhance vitality, immunity, and wholesome body functioning; hence, they can easily fulfil daily nutritional requirements at all times.
(Disclaimer: At Health Shots, we make a constant effort to break the clutter for our readers. All products listed are carefully curated by the editorial team but use your discretion and an expert’s opinion before using them. Their price and availability may differ from the time of publication. If you buy something using these links in the story, we may earn a commission.)